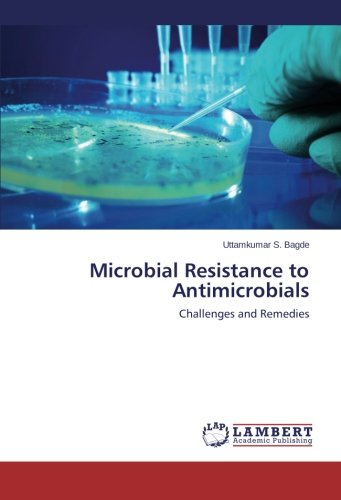

Everyone would love to read. We have a large collection of books on this website.
One of them is a book Microbial Resistance to Antimicrobials: Challenges and Remedies PDF Download that is very nice, interesting, and definitely you like. This is the best book that will take you as if you are participating in the story.
Just click download and book Microbial Resistance to Antimicrobials: Challenges and Remedies you can get for free on this website. Books are available in PDF, Kindle, Ebook, ePub and mobi formats.
You can also read it directly on this website. Hurry, download the book Microbial Resistance to Antimicrobials: Challenges and Remedies PDF Kindle immediately.
Microbial Resistance to Antimicrobials: Challenges and Remedies PDF Download
How to read Microbial Resistance to Antimicrobials: Challenges and Remedies PDF ePub ... by ... online and download? Simply FREE SIGN UP and get 7-day trial to read Microbial Resistance to Antimicrobials: Challenges and Remedies ... by ... and download Microbial Resistance to Antimicrobials: Challenges and Remedies ... by ... PDF EPub Kindle ...
Microbial Resistance to Antimicrobials: Challenges and Remedies has ... ratings and ... reviews. Reads Blog said I think I fell in love with ... writing a little bit ...
PDF online books Microbial Resistance to Antimicrobials: Challenges and Remedies PDF Free ... by ... with other formats. Download and Read Online books Microbial Resistance to Antimicrobials: Challenges and Remedies ... Online ... its easy way to download Microbial Resistance to Antimicrobials: Challenges and Remedies ... books for multiple devices.
Microbial Resistance to Antimicrobials: Challenges and Remedies ... eBook ... Kindle Store. Download it once and read it on your mobile now
Microbial Resistance to Antimicrobials: Challenges and Remedies PDF Kindle edition by ... Download it once and read it on your Kindle device, PC, phones or tablets. Use features like bookmarks, note taking and highlighting while reading Microbial Resistance to Antimicrobials: Challenges and Remedies
Read Microbial Resistance to Antimicrobials: Challenges and Remedies book reviews and author details and more at ... Free title on ... Kindle. Learn more .... have a Kindle? Get your Kindle here, or download a FREE Kindle Reading App.
No comments:
Post a Comment